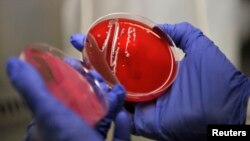
Soj bakterije escherichie coli

Sa tržišta Bosne i Hercegovine (BiH) još nije povučeno sedam brendova flaširane vode za koje je Zavod za javno zdravstvo Federacije BiH (ZZJZ) još prije tri sedmice utvrdio da sadrže opasne bakterije.
Ovo je za Radio Slobodna Evropa (RSE) potvrdio direktor Agencije za sigurnost hrane BiH, Džemil Hajrić.
ZZJZ Federacije BiH je 17. novembra objavio da je analizirao 70 uzoraka flaširane vode iz trgovina.
Naveli su da je sedam uzoraka sadržavalo opasne bakterije, uključujući escherichiju coli i fekalne streptokoke, koje mogu uzrokovati mokraćne i crijevne infekcije, koleru, tifusu, slamonelozu i gastroenteritis.
Međutim, ZZJZ od tada odbija saopštiti o kojim se brendovima flaširane vode radi, što je izazvalo brojne reakcija javnosti i medija.
Analiza flaširane vode, koju je uradio ZZJZ, nije provedena u skladu sa zakonom, jer nisu bile uključene nadležne inspekcije, niti Agencija za sigurnost hrane BiH, rekao je Hajrić za RSE.
"Analiza koju je proveo Zavod za javno zdravstvo FBiH ne može biti zakonski osnov za povlačenje proizvoda sa tržišta i pokretanje pravnih postupaka protiv proizvođača za eventualnu odgovornost", potvrdio je direktor Agencije za sigurnost hrane BiH, Džemil Hajrić.
On dodaje da je Agencija inicirala inspekcijski nadzor, motivisana panikom javnosti.
"Nadležne inspekcije u entitetima i kantonima već nekoliko dana provode kontrole na terenu i analiziraju prikupljene uzorke", kaže Hajrić.
Prema njegovim riječima, zvanični rezultati će biti objavljeni "za koji dan".
"Do sada urađene analize pokazale su da stanje nije onakvo kako ga je prikazao Zavod za javno zdravstvo Federacije BiH prije dvadesetak dana", ističe Hajrić.
U Agenciji za sigurnost hrane BiH kažu da je u BiH dozvoljena prodaja 67 brendova mineralne i izvorske vode.
Zašto Zavod ne objavljuje informacije?
Već nekoliko dana u Zavodu za javno zdravstvo Federacije BiH se niko ne javlja na telefon.
Na upit RSE o tome zbog čega još nisu objavili informaciju u kojim flaširanim vodama su pronašli bakterije, nije odgovoreno ni mailom.
Novinar RSE je 8. decembra posjetio Zavod, čije je sjedište u Sarajevu, kako bi dobio informaciju zbog čega se niko ne javlja na telefon, te da li postoji mogućnost da se izjava snimi na licu mjesta.
Portparolka ove institucije Maja Kojović je kazala za RSE isti dan kako ne može dati zvaničnu izjavu o nastaloj situaciji, te da direktor Siniša Skočibušić nije u zgradi.
Podnesena tužba protiv Zavoda
Banjalučki advokat Dario Sandić podnio je krivičnu prijavu protiv direktora Zavoda za javno zdravstvo FBiH.
To je uradio, kako kaže za RSE, nakon što mu Zavod nije odgovorio na zahtjev za pristup informacijama. On je od Zavoda tražio podatke o tome koje flaširane vode sadrže opasne bakterije.
Prijavu je podnio 6. decembra Tužilaštvu Federacije BiH.
"Smatrao sam kao obavezu da podnesem krivičnu prijavu protiv direktora Zavoda, obzirom da on rukovodi tom ustanovom i da je dužan da takve informacije podijeli sa građanima, jer od tih informacija može da zavisi zdravlje i život građana", navodi Sandić za RSE.
Kako ističe, Tužilaštvo Federacije Bosne i Hercegovine "bi trebalo što hitnije da sprovede istražne radnje, te da se utvrdi zašto direktor nije objavio koje vode nisu podobne za piće za građane BiH".
"Nema ovo apsolutno nikakve veze što se radi o tržištu Federacije BiH, jer smatram da 95 posto voda koje se prodaju u FBiH, prodaju se i na teritoriji Republike Srpske, tako da sam smatrao da je to moja građanska i pravnička dužnost da učinim što mogu od sebe", kaže on.
Na pitanje RSE da li ga je neko kontaktirao iz Tužilaštva Federacije BiH, Sandić odgovara da pravna procedura nije tako brza, ali da je mislio da će reagovati inspekcija.
"Ja sam ovdje naveo više krivičnih djela, ali za svako djelo je predviđena kazna zatvora. Koliko se sjećam, ne znam sad tačno, radi se o ugrožavanju zdravlja, zloupotrebi položaja i ovlaštenja, omogućavanje prodaje štetnih materija i tako dalje", dodaje Sandić.
Iz Federalnog tužilaštva za RSE navode da nisu nadležni, te da su krivičnu prijavu proslijedili nadležnom Kantonalnom tužilaštvu Sarajevo.
Istovremeno, u Federalnoj upravi za inspekcije poslove za RSE ističu kako su dobili informacije o rezultatima istraživanja Zavoda za javno zdravstvo FBiH krajem oktobra. Nakon toga su počeli kontrolu, uključivši kantonalne i opštinske inspekcije.
"Kontrola inspekcija se privodi kraju, te se očekuju i rezultati preostalih laboratorijskih analiza prikupljenih uzoraka. Prema dosadašnjim podacima kantonalnih inspekcija, u do sada izvršenim nadzorima sporne vode nisu zatečene na tržištu, niti je laboratorijskim analizama utvrđena neusklađenost uzoraka", navodi se u odgovoru za RSE.
Ko radi kontrolu hrane i pića u BiH?
U Agenciji za sigurnost hrane BiH kažu za RSE kako zakonski jedino ovlašteni inspektori mogu uzeti uzorke hrane i pića na tržištu. Nakon toga se sačinjava zapisnik koji mora sadržavati podatke o seriji uzrokovanog proizvoda, mjestu i vremenu uzorkovanja.
"O svemu inspekcija obavještava i proizvođača, kako bi imao pravo da traži izuzimanje i kontrolnog uzorka iz iste serije, za eventualno kasnije supervještačenje u slučaju sudskog ili nekog drugog spora", kaže Hajrić za RSE.
On ističe da je važno smiriti paniku u javnosti, te da sva hrana i voda u trgovinama prolazi kontrolu u skladu sa evropskim standardima.
Šta kažu građani?
Građanka Sarajeva, koja nije željela da se predstavi, kaže kako kupuje vodu, jer ima problem sa bubrezima. Uglavnom kupuje vodu iz Srbije.
"Ne znam ko koga štiti ovdje. Ovo što oni neće da objave, zato ih treba tužiti", ističe ona.
Sarajlija Mihajlo kaže da uglavnom pije vodu iz česme, te da kupuje jedino kada voda iz gradskog vodovoda bude zamućena.
"Čuo sam informaciju da su objavili da je voda neispravna. To je spinovanje javnosti. Ako imaš podatke da je voda zagađena, onda objaviš podatke, a ne ovako", navodi Mihajlo.
"Kako može utvrditi koja voda ima opasne bakterije, a ne reći koja je u pitanju. Znači, svjesno nas truju", poručuje Huso.
Uvoz i izvoz vode
Bosna i Hercegovina je u prvih deset mjeseci ove godine uvezla oko 180 miliona litara vode, čija je vrijednost veća od 99 miliona eura, prema podacima Vanjskotrgovinske komore BiH.
Tako je, praktično, za deset mjeseci ove godine uvezeno više vode nego tokom cijele 2021. godine.
BiH je izvezla u prvih deset mjeseci 2022. godine oko 100 miliona litara vode čija je vrijednost oko 22 miliona eura.
Najviše vode se uvozi iz Hrvatske, Srbije i Slovenije.